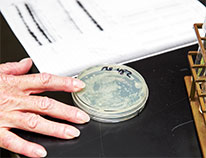

CU Maps Unexplored Genome Region
CU School of Medicine Oct 17, 2019
Photonics →

Thousands of people volunteer for clinical trials each year at the School of Medicine. Some offer payment; others give free health exams and follow-up.
View the CU Anschutz Clinical Trials Website for volunteer opportunities.